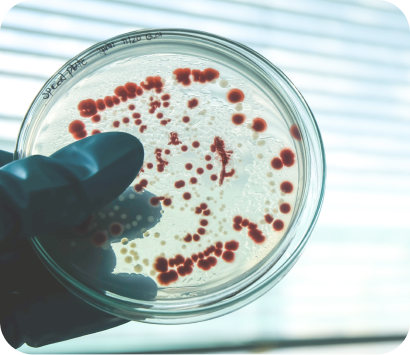

Sicheres Wasser für Deine Familie
Kommt dir das bekannt vor?
Alles zu umständlich? Das finden wir auch!
Wir haben die unkomplizierte Lösung: Der HYPRO WATER garantiert Dir und Deiner Familie Leitungswasser frei von Viren, Bakterien, Blei, Kupfer und vielem mehr. Direkt aus Deinem Wasserhahn.
Mit dem HYPRO WATER
- Sparst Du Zeit: Kein Abkochen, kein Abkühlen
- Vermeidest Du anstrengendes Flaschen-Schleppen
- Sparst du Dir das teure Babywasser
Warum Du Leitungswasser aufbereiten solltest?
Für die Zubereitung von Babynahrung und auch als Durstlöscher selbst ist das normale Leitungswasser für Babys nicht empfehlenswert. Die Deutsche Trinkwasserverordnung schreibt die Höchstgrenzen für Schad- und Mineralstoffe vor, die von den Wasserwerken eingehalten werden müssen. Diese Höchstwerte sind jedoch viel zu hoch für ein Baby!
Mit dem HYPRO WATER kann das Wasser so aufbereitet werden, dass Dein Baby das gefilterte Wasser trinken kann. Wasserhahn auf - und sofort keimfreies Wasser zapfen!
Unser HYPRO WATER entfernt jedoch keine Mineralien wie Calcium, Magnesium, Natrium, Nitrat und Sulfat aus dem Wasser. Deshalb sollten Eltern mittels einer Trinkwasseranalyse testen, ob der Gehalt an Natrium, Nitrat und Sulfat gering ist, denn diese Mineralien sollten Babys und Kleinkinder nur in geringen Dosen zu sich nehmen.
Mehr Informationen findest Du in unserem Blogbeitrag.
FAQ
Häufig gestellte Fragen
HYPRO WATER PRODUKTINFOS
Für die Anmeldung im Haushaltsbereich für UVC-LED-Wasseraufbereitungsgeräte gibt es keinen verpflichtenden Standard. Wir haben uns als Ziel gesetzt, das beste Wasseraufbereitungsgerät der Welt zu entwickeln. Die von uns vorgestellten und bestandenen Standards sind alle freiwillig von uns durchgeführt worden.
Hier findest Du unsere Zertifikate.
Die nachgelagerte UVC-LED-Einheit schaltet sich automatisch in regelmäßigen Abständen ein und führt eine Selbstdesinfektion durch. So entstehen keine Keime im Gerät.
Die UVC-LED-Einheit hat viele Langzeittests durchlaufen und hat eine Lebensdauer von 10.000 Stunden. Sie müssen nicht ausgetauscht werden. Bei 20minütiger Nutzung pro Tag entspricht die Lebensdauer der LEDs also 83 Jahre.
Der einzige Wartungsaufwand ist damit der Filterwechsel, der 3x pro Jahr ansteht. Der Austausch ist kinderleicht, hier kannst Du Dir unser Video dazu anschauen.
Wasser aus dem HYPRO WATER hat einen 300x kleineren ökologischen und CO² Fußabdruck als herkömmliches Flaschenwasser. Anders als andere Wasserfilter desinfiziert der HYPRO WATER Dein Trinkwasser vollkommen chemiefrei und ohne Abwasser/ Schmutzwasser zu produzieren.
Unsere Produktion erfolgt in Deutschland und wir verwenden hochwertigste Materialien. Die verwendete Aktivkohle im Filter wird z.B. nachhaltig aus Kokosnussschalen gewonnen.
In unserem Unternehmen schreiben wir Umweltbewusstsein groß. So sind wir Mitglied im B.A.U.M. e.V., einem Netzwerk für nachhaltiges Wirtschaften.
Mehr Informationen zum Thema Nachhaltigkeit findest Du hier.
Ja, jeder kann das Gerät ganz einfach selbst zu Hause anschließen. Dazu einfach den Schritten in der Bedienungsanleitung folgen oder das Installationsvideo für den 3-Wege-Hahn oder den 2-Wege-Hahn ansehen.
Allerdings kannst Du jeden Sanitärfachbetrieb oder Hausmeisterservice aus Deiner Umgebung mit der Montage beauftragen, diese ist kinderleicht.
Für Servicefragen steht Dir unser Team per Telefon, Chat oder E-Mail zur Verfügung.
Das Produkt selbst verfügt über ein Sicherheitsventil. Sollte (z.B. aufgrund der fehlerhaften Installation) Wasser austreten, löst das Ventil aus und der Wasserzufluss wird gestoppt, sodass es in Deiner Küche nicht zu einem Wasserschaden kommen kann.
Der HYPRO WATER ist ein kleines Trinkwasserwerk für Dein zu Hause. Mit einer Größe von 25x24x16 cm findet er in jeder Küche Platz.
Du benötigst nur einen Strom- und einen Kaltwasseranschluss.
Der HYPRO WATER wird von den meisten unserer Kunden unter der Arbeitsplatte platziert. Mit einer Größe, die mit einem Toaster vergleichbar ist, passt er auch super in Schubladen direkt unter der Spüle.
Der HYPRO WATER kann dank seiner kompakten Größe auf der Arbeitsplatte platziert werden. Bitte beachte, dass Du dazu ein kleines Loch für Schläuche und das Stromkabel benötigen wirst.